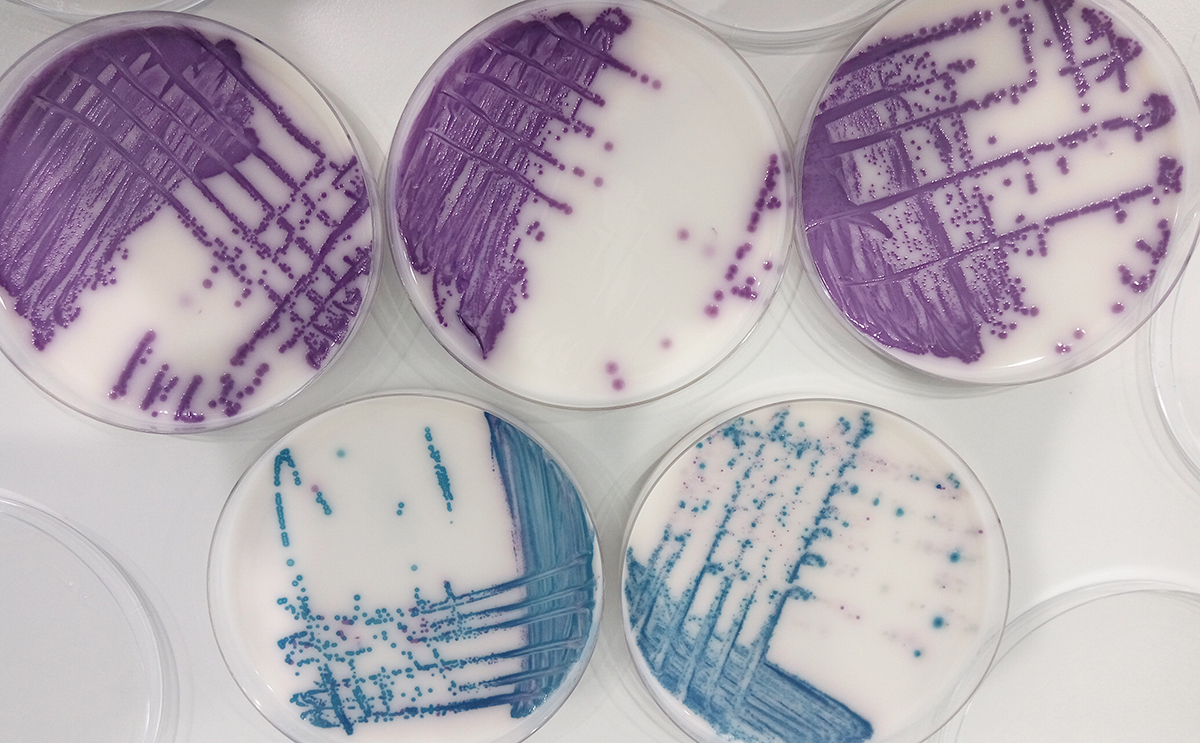
Leartiker tweet media

Gomiztegi Koop retweetledi

🐄Puertas abiertas-BEHIZAIN ESKOLA-Ate irekiak
📷Maiatzak 26 Mayo 11:30
📷 663776218
📷youtu.be/zUsHrZFXGhE
@EkoGarapena @BittorOroz @gomiztegi

YouTube
Euskara
Gomiztegi Koop
193 posts

@gomiztegi
Artzain Eskola. Ardiak, Gaztak eta bisitaldiak. School of Shepherds. Sheep, Cheese and Visits. Escuela de Pastores. Ovejas, Quesos y Visitas.






PRODUKTU EKOLOGIKOAK. SINPLEA ETA ULERTERRAZA DA EKUAZIOA: AZKEN-PRODUKTUA EKOIZTEN DEN TOKIAN BERTAN SALTZEN EZ BADUGU, EZ DA EKOLOGIKOA. ETA GURE GANADUAK JATEN DUENA TOKIAN BERTAN EKOIZTEN EZ BADA, EZ DA EKOLOGIKOA.




beigorri.eus/eu/ EHko okela on-line zure etxera. 664 85 40 08